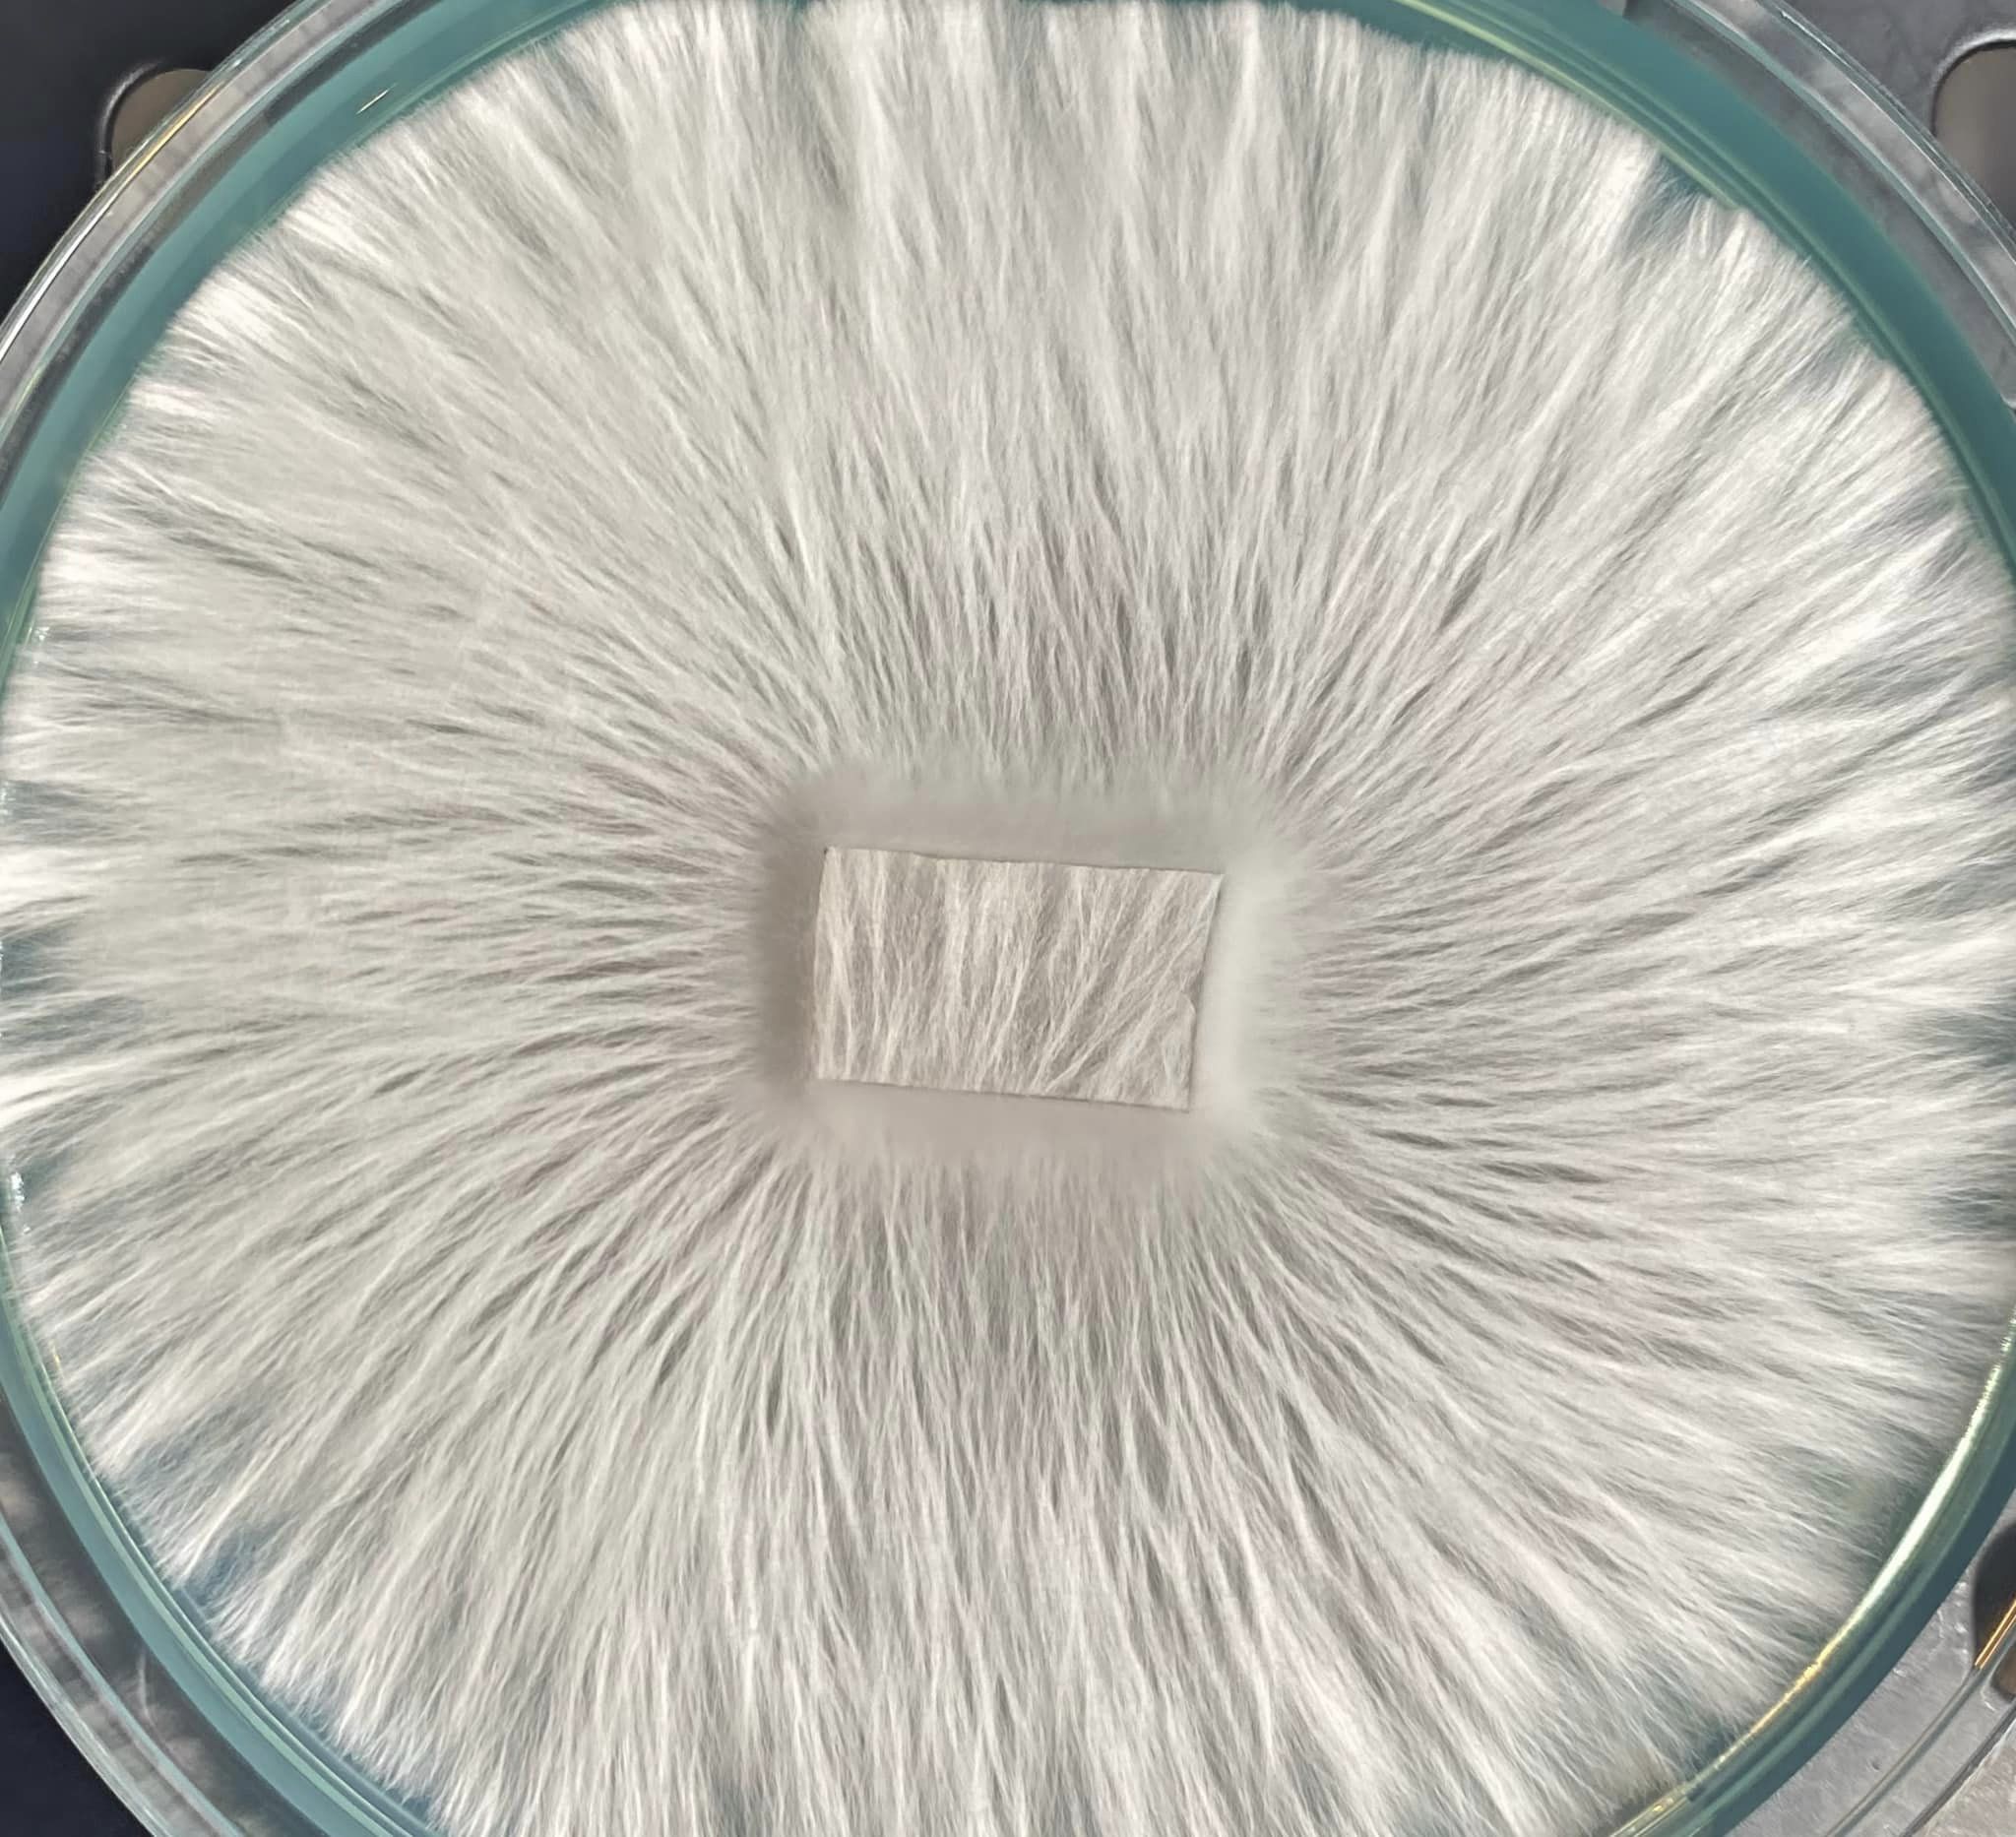

Humble Bruise
Actives, Cultures
Albino Melmak Research Plate
$23.50
Albino Isolation of Melmak PE
100mm x 15mm agar plate
Research Plates are made to order and may take up to 10 days before shipment. All plates will have varying growth patterns depending on the genetic differences of each culture. For microscopy research purposes only.
Units Sold: 3
Terms and Conditions
All items for sale are for microscopy research only.
Shipping costs
| Shipping from | United States (US) |
| Within United States (US) | $5.50 |
National Shipping Details
| Minimum shipping charge per order | $5.50 |
| Maximum shipping charge per order | $5.50 |